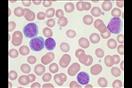

قصة امرأة أنقذها ألم في مرفقيها من سرطان مميت.. وهذا ما حدث
كتبت- شيماء مرسي
-
عرض 5 صورة
-
عرض 5 صورة

-
عرض 5 صورة

-
عرض 5 صورة

-
عرض 5 صورة

عندما عانت امرأة بريطانية تدعى "ديان كيندريد" لأول مرة من ألم في مرفقيها، لم تكن تعتقد أبدًا أن سبب الألم هو إصابتها بسرطان مميت.
وتم تشخيص إصابة المرأة البالغة من العمر 53 عامًا بسرطان الدم بعد أن حثها أخصائي العلاج الطبيعي على إجراء فحص الدم.
وبعد أن أنقذ الطبيب حياتها رغبت في حث الآخرين حتى يكونوا على دراية بالعلامات التحذيرية بالمرض، وفقا لصحيفة "إكسبريس" البريطانية.
وقالت: "عندما شعرت بألم في مرفقي ذهبت إلى الطبيب فورا في مستشفى الملكة إليزابيث بإنجلترا".
وقال الأطباء إن هناك تلفاً في الأعصاب بسبب المرفقين ولكنها أصرت على إجراء فحص الدم.
وكانت ديان من مدينة نيوكاسل، بإنجلترا، وأثناء تواجدها مع زوجها تلقت أخبارًا مزعجة مفادها أنها بحاجة إلى الذهاب إلى المستشفى على وجه السرعة.
وكشفت اختبارات الدم الإضافية وخزعة النخاع العظمي أنها مصابة بسرطان الدم الليمفاوي الحاد.
وسرطان الدم الليمفاوي هو نوع من سرطان الدم يبدأ من خلايا الدم البيضاء التي تسمى الخلايا الليمفاوية الموجودة في نخاع العظم.
وعلى الرغم من أنه أكثر شيوعًا عند الشباب، إلا أنه يؤثر في أي شخص في أي عمر.
ولحسن حظ ديان، تم اكتشاف السرطان الذي تعانيه في مرحلة قابلة للعلاج.
وتبرعت لها شقيقتها بالخلايا الجذعية وخضعت لعملية زرع ناجحة.
وبعد مرور خمس سنوات، وبعد المزيد من العلاجات، أصبحت الآن خالية من السرطان.
الأعراض الرئيسية لسرطان الدم التي يجب البحث عنها:
البشرة الشاحبة
التعب
ضيق التنفس
فقدان الوزن دون محاولة
الالتهابات المتكررة
ارتفاع درجة الحرارة والشعور بالسخونة أو الارتعاش (الحمى)
التعرق الليلي
نزيف غير عادي ومتكرر من اللثة أو الأنف
كدمات الجلد
ظهور بقع حمراء أو أرجوانية مسطحة على الجلد
آلام العظام والمفاصل
الشعور بالامتلاء أو عدم الراحة في بطنك
تورم الغدد في رقبتك أو الإبط أو الفخذ
اقرأ أيضا:
4 فئات ممنوعة من تناول كبد وقوانص الدجاج- هذا ما يحدث لهم
سيدة تعاني من أعراض خفية كشفت إصابتها بسرطان خطير
أبراج تفضل تناول حلوى المولد بشراهة.. هل أنت منهم؟
عامل توصيل يبصق على الطعام أمام منزل العميل (فيديو)
خبيرة تكشف: هذه الأبراج تتأثر بالحسد والعين بسهولة






















